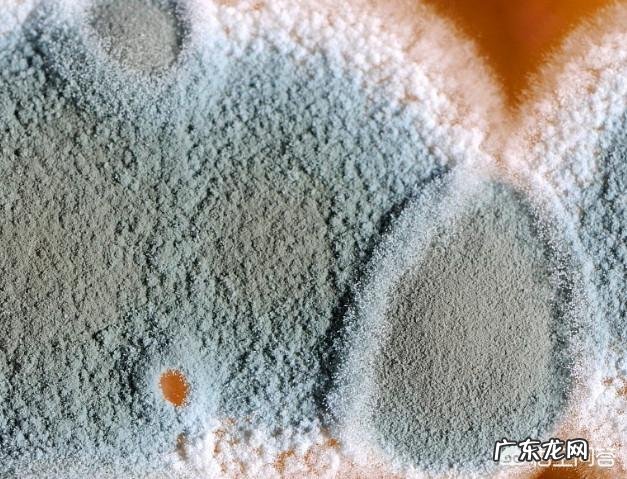
医生说:肝癌是吃出来的,爱吃哪些食物容易得肝癌

今年46的王阿姨,最近总是很疲惫,总是想躺着,总觉得累 。

文章插图
而且体重明显的下降,也不爱吃东西,情况越来越不好 。

文章插图
王阿姨就去一件检查一下,结果王阿姨被确诊为肝癌 。
文章插图
医生建议必须马上入院zhi疗,病情很严重 。

文章插图
可是家人都不明白,王阿姨,不吸烟也不喝酒,平时身体也不错啊 。

文章插图

文章插图
怎么就换上肝癌,经过了解,医生提醒:这种“水果”,最好扔掉!

文章插图
原来,王阿姨家是开水果店的,平时经常吃的就是——烂水果 。

文章插图
家里也是小本生意,烂水果也不能买个客人,自己又舍不得扔,

文章插图
水果也有营养,这些年了,王阿姨总是吃一些挑挑拣拣的水果吃 。

文章插图
这也是促进肝癌发生的主要的因素 。
腐烂的水果,最好扔掉
腐烂的水果中,含有较高的就是展青霉素,长期的摄入会引起消化系统的紊乱 。
展青霉素与细胞膜结合,造成不可逆的细胞的长期损伤,产生癌变 。
腐烂的水果中,也含有大量的黄曲霉素,是直接破坏肝脏细胞,引起肝脏疾病 。
其中也含有大量的亚硝酸盐,引起肝脏中毒,增加癌变的几率 。
此外,以下几种物质,也最好扔掉,切莫舍不得!
1、存储时间长的花生
长时间存储的花生,不仅失去大量的营养物质 。
同时也会发生霉变,遭受霉菌,细菌等物质的侵蚀,也会滋生黄曲霉菌 。
如使用不当,会引起中毒,身体脏器的负担,容易诱发疾病 。
2、变苦的坚果
变苦的坚果中已经产生大量的黄曲霉素 。
黄曲霉素是一种剧毒,其毒性为氰化钾的10倍,为砒霜的68倍 。
尤其是是直接对肝脏产生损伤,诱发肝炎,肝硬化,肝癌的发生 。
3、漂亮的无根豆芽
越是看着好看的豆芽,越是经过加工和处理的 。
研究发现,很多豆芽都是经过工业漂白粉处理过的 。
如长期的食用,会增加消化道,粘膜组织的损伤,严重营养肝肾的代谢 。
鉴别:毒豆芽一般会很轻易的断掉,自然生长的豆芽韧性好 。
4、哈喇味的油
食用油是我们一年四季不能缺少的,所以很多人会大量的储存,尤其是乡下 。
有哈喇味的油,其中的蛋白质结构已经遭到破坏,发生变异 。
有些有毒物质,会加速人的衰老,像癌细胞转化,诱发疾病的发生 。
养护肝脏健康,预防肝脏癌变,教你四件事!
一、多补硒,清肝毒
硒,是人体必需元素,需要从食物中摄取 。
我国卫生部2017年指出,成年人推荐硒每日摄取量60微克,最高可摄入400微克 。
硒是肝脏的“天敌”,有抵御肝炎,预防肝脏疾病的作用 。
研究发现,肝病患者普遍缺硒 。
硒进入体内,可保护肝细胞健康完整、加速脂质过氧化物分解、提高肝脏自身抗病能力,被称为“强效免疫调节剂” 。
- 减肥用药应在医生指导下进行
- 我得了双向情感障碍,该不该吃医生开的药
- 男人40岁,出现“哪4少”,说明健康值在急速下降
- 褪黑素正确说法 专家讲解褪黑素
- 37岁小伙患胃癌晚期,医生说这些习惯害了他,是哪些习惯啊
- 泰国有哪些颜值很高的女星
- 20岁大学生吹空调吹进ICU!近期高发!医生紧急提醒…
- 女生腿又粗又短,该怎么办
- 水果滞销,谁打烂了这副牌
- 乳腺小叶增生,医生说不用吃药,不要生气,一直疼怎么办
特别声明:本站内容均来自网友提供或互联网,仅供参考,请勿用于商业和其他非法用途。如果侵犯了您的权益请与我们联系,我们将在24小时内删除。
